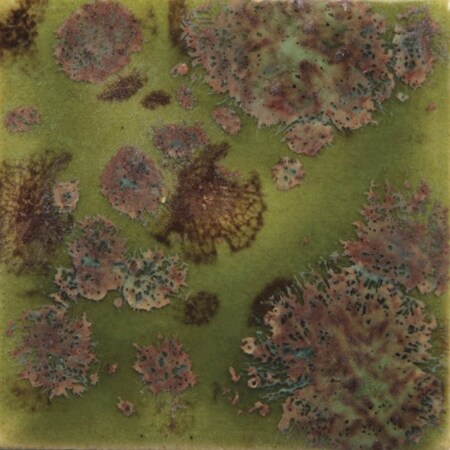
Sax True Flow Colorburst Glaze, Pagoda Green, 1 Pint S2614X

Get a 10% off coupon
Free 30-day returns
Return PolicyGet 30 days to pay with Net 30
Apply NowUnlock tax-exempt savings
Add Tax ExemptionSpecifications
Product Information
MFR #
S2614X
Zoro #
G902661771
UPC #
885634261276
Country of Origin
United States
Description
Sax True Flow Pagoda Green Colorburst Glaze is Semi-Opaque and is ideal for one-of-a-kind pieces since every application and every firing will produce different results. Creates multi-colored patterns as well as designs when fired. Create unique dramatic effects by combining other glazes of a similar firing range. Color turns gold brown and crystals will be orange with blue/purple halo. Freeze/Thaw stable. Not dinnerware safe due to surface characteristics.
Restrictions
Hazardous material
Ratings & Reviews
3 Reasons You Can Count On Us
Supplies for every job.
10 million items and the exact one you need.
When you need it fast, count on Zoro!
2 million products ship in 1 day.
Stretch your budget further.
Everyday low prices on the brands you love.